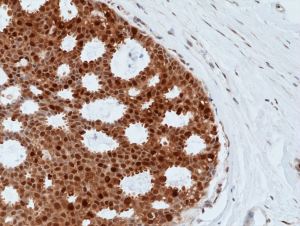
Anti-BAG-1 (human), Rabbit Monoclonal (RM356)

Cookie preferences
This website uses cookies, which are necessary for the technical operation of the website and are always set. Other cookies, which increase the comfort when using this website, are used for direct advertising or to facilitate interaction with other websites and social networks, are only set with your consent.
Configuration
Technically required
These cookies are necessary for the basic functions of the shop.
"Allow all cookies" cookie
"Decline all cookies" cookie
CSRF token
Cookie preferences
Currency change
Customer-specific caching
FACT-Finder tracking
Individual prices
Selected shop
Session
Comfort functions
These cookies are used to make the shopping experience even more appealing, for example for the recognition of the visitor.
Note
Show the facebook fanpage in the right blod sidebar
Statistics & Tracking
Affiliate program
Conversion and usertracking via Google Tag Manager
Track device being used
| Item number | Size | Datasheet | Manual | SDS | Delivery time | Quantity | Price |
|---|---|---|---|---|---|---|---|
| REV-31-1242-00-R100 | 100 µl | - | - |
3 - 9 business days* |
541.00€
|
If you have any questions, please use our Contact Form.
You can also order by e-mail: info@biomol.com
Larger quantity required? Request bulk
You can also order by e-mail: info@biomol.com
Larger quantity required? Request bulk
Recombinant Antibody. This antibody reacts to total human BAG-1 protein, including long (BAG-1L),... more
Product information "Anti-BAG-1 (human), Rabbit Monoclonal (RM356)"
Recombinant Antibody. This antibody reacts to total human BAG-1 protein, including long (BAG-1L), medium (BAG-1M) and short (BAG-1S) isoforms. Applications: WB, IHC. Source: Rabbit. Liquid. 50% Glycerol/PBS with 1% BSA and 0.09% sodium azide. BAG-1 belongs to a family of evolutionary conserved proteins, containing an approximately 110 amino acid sequence termed the BAG domain that defines the protein family. BAG1 was identified in a screen of interacting proteins of the anti-apoptotic protein BCL2. BAG1 shares no significant homology with BCL2 or other BCL2 family proteins, which can form homo- and heterodimers. However, coexpression of BAG1 and BCL2 provided markedly increased protection from cell death induced by several stimuli. BAG1 itself is made up of different isoforms translated from a single mRNA by alternative translational initiation, resulting in similar carboxy-terminal sequences but different N-terminal sequences. In humans, there are four BAG1 isoforms (BAG1L, 1M, 1 and 1S). The multiple protein isoforms interact with diverse partners, including chaperones Hsc70/Hsp70, Ser/Thr kinase Raf-1 and Bcl-2, to promote cancer cell survival. The BAG-1L isoform specifically binds to and increases the transcriptional activity of oestrogen receptor in cells, and in some, but not all studies, BAG-1 expression is predictive of clinical outcome in breast cancer.
| Keywords: | Bcl-2-associated Athanogene 1, BAG Family Molecular Chaperone Regulator 1 |
| Supplier: | RevMAb Biosciences |
| Supplier-Nr: | 31-1242-00 |
Properties
| Application: | WB, IHC |
| Antibody Type: | Monoclonal |
| Clone: | RM356 |
| Conjugate: | No |
| Host: | Rabbit |
| Species reactivity: | human |
| Format: | Purified |
Database Information
| KEGG ID : | K09555 | Matching products |
| UniProt ID : | Q99933 | Matching products |
| Gene ID : | GeneID 573 | Matching products |
Handling & Safety
| Storage: | -20°C |
| Shipping: | +4°C (International: +4°C) |
Caution
Our products are for laboratory research use only: Not for administration to humans!
Our products are for laboratory research use only: Not for administration to humans!
Information about the product reference will follow.
more
You will get a certificate here
Viewed

